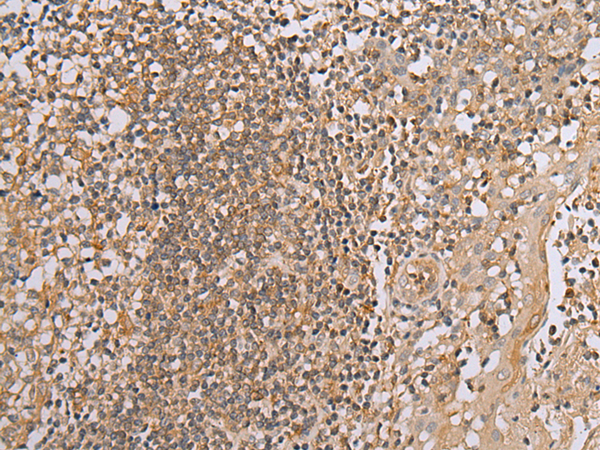

中文名稱:兔抗BAG2多克隆抗體
|
Background: |
BAG proteins compete with Hip for binding to the Hsc70/Hsp70 ATPase domain and promote substrate release. All the BAG proteins have an approximately 45-amino acid BAG domain near the C terminus but differ markedly in their N-terminal regions. The predicted BAG2 protein contains 211 amino acids. The BAG domains of BAG1, BAG2, and BAG3 interact specifically with the Hsc70 ATPase domain in vitro and in mammalian cells. All 3 proteins bind with high affinity to the ATPase domain of Hsc70 and inhibit its chaperone activity in a Hip-repressible manner. |
|
Applications: |
ELISA, WB, IHC |
|
Name of antibody: |
BAG2 |
|
Immunogen: |
Synthetic peptide of human BAG2 |
|
Full name: |
BCL2-associated athanogene 2 |
|
Synonyms: |
BAG-2; dJ417I1.2 |
|
SwissProt: |
O95816 |
|
ELISA Recommended dilution: |
5000-10000 |
|
IHC positive control: |
Human tonsil and human esophagus cancer |
|
IHC Recommend dilution: |
30-150 |
|
WB Predicted band size: |
24 kDa |
|
WB Positive control: |
Human fetal muscle tissue,HEPG2,Jurkat,Hela,A431 and A549 cell |
|
WB Recommended dilution: |
500-2000 |

購物車
幫助
021-54845833/15800441009
